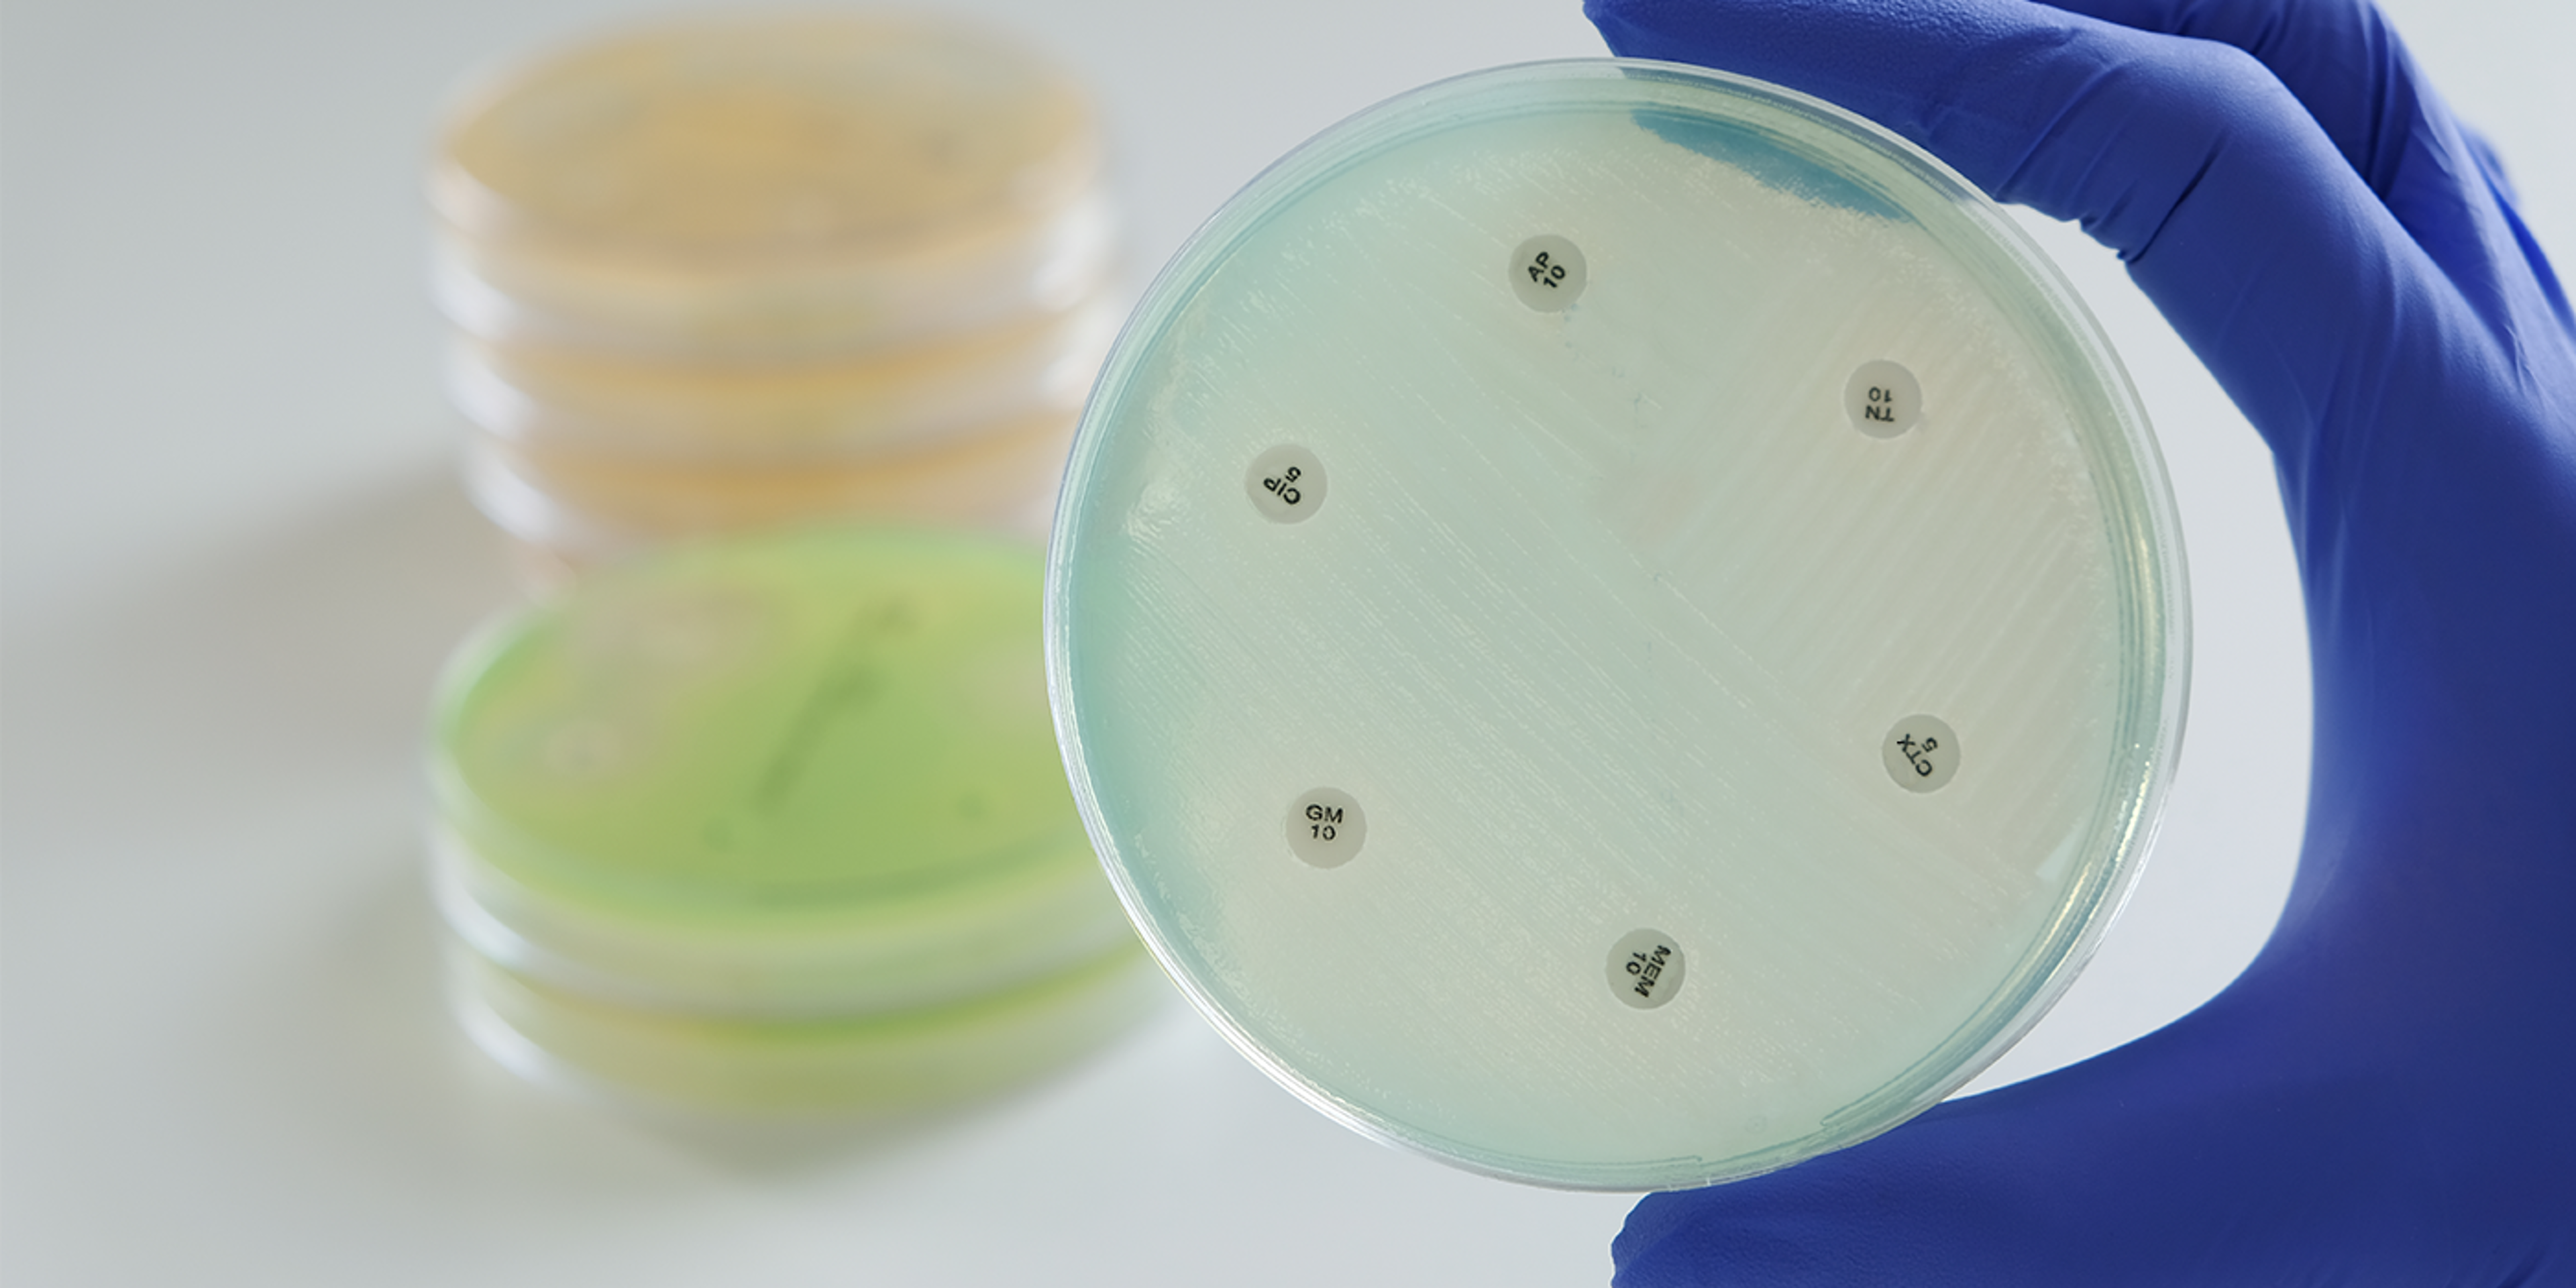
Pioneers in AST
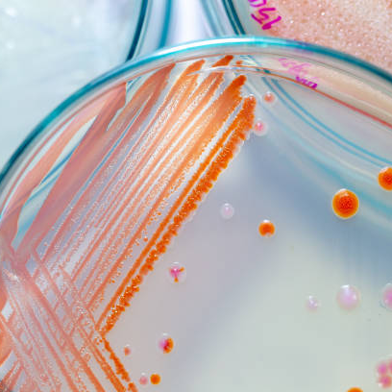
Microbiology.png

Trusted diagnostic solutions for labs worldwide
Innovative, ISO-certified diagnostic solutions serving labs worldwide


Mast Group wins award at Pharma Industry Awards!
Mast Group wins "Best Patient-Centric Initiative" at the Pharma Industry Awards UK
Pioneers in AST
Discover our expanding range of AST products for the determination of bacterial and fungal antibiotic susceptibility in the treatment of infectious disease

A Legacy of Scientific Innovation
Our vision is to be a global innovative solutions provider, manufacturer and supplier of in vitro diagnostic products and services. For over 65 years, we’ve provided diagnostic products that have resulted in improved clinical decisions and pathways.
Explore our Diagnostic Solutions
From being one of the pioneers of the AST disc, Mast’s product range has evolved to support accurate, reliable diagnostics across clinical, veterinary and research settings.